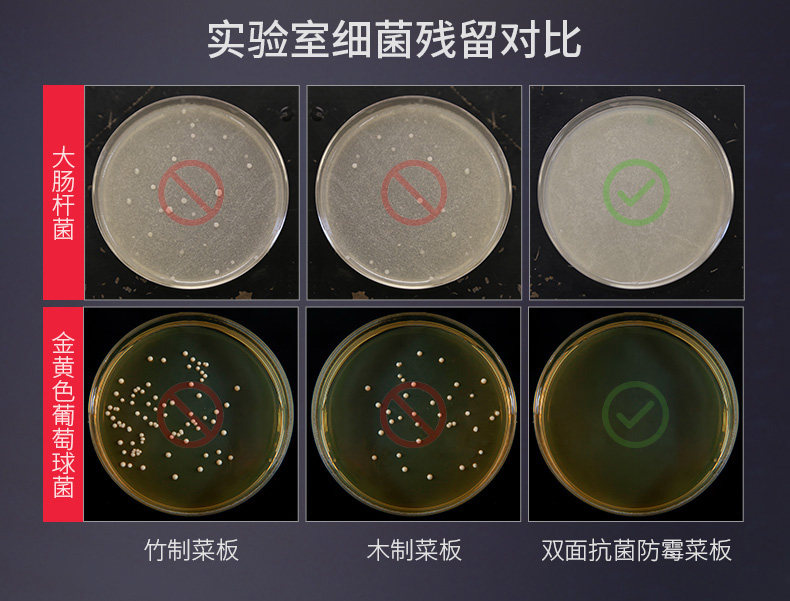

Антибактериальная двусторонная пластиковая разделочная доска из нержавеющей стали, Германия, увеличенная толщина

Цена: 1 860-2 705руб. (¥88)
Артикул: 613341061096
Вес товара: ~0.7 кг. Указан усредненный вес, который может отличаться от фактического. Не включен в цену, оплачивается при получении.
Описание товараPGltZyBjbGFzcz0iZGVzY19hbmNob3IiIGlkPSJkZXNjLW1vZHVsZS0xIiBzcmM9Imh0dHBzOi8vYXNzZXRzLmFsaWNkbi5jb20va2lzc3kvMS4wLjAvYnVpbGQvaW1nbGF6eWxvYWQvc3BhY2ViYWxsLmdpZiI+PHA+PGltZyBzcmM9Imh0dHBzOi8vaW1nLmFsaWNkbi5jb20vaW1nZXh0cmEvaTEvNDI0MzY3OTI0Mi9PMUNOMDEwSHhVYjIySTh0NFc0OGhqQ18hITQyNDM2NzkyNDIuanBnIiBhbGlnbj0iYWJzbWlkZGxlIj48aW1nIHNyYz0iaHR0cHM6Ly9pbWcuYWxpY2RuLmNvbS9pbWdleHRyYS9pMi80MjQzNjc5MjQyL08xQ04wMXZTeVpFaDJJOHQ0WHRvNTNIXyEhNDI0MzY3OTI0Mi5qcGciIGFsaWduPSJhYnNtaWRkbGUiPjxpbWcgc3JjPSJodHRwczovL2ltZy5hbGljZG4uY29tL2ltZ2V4dHJhL2kzLzQyNDM2NzkyNDIvTzFDTjAxcEJoWGE1Mkk4dDRMQXg1ekNfISE0MjQzNjc5MjQyLmpwZyIgYWxpZ249ImFic21pZGRsZSI+PGltZyBzcmM9Imh0dHBzOi8vaW1nLmFsaWNkbi5jb20vaW1nZXh0cmEvaTIvNDI0MzY3OTI0Mi9PMUNOMDE4eHlWTzcySTh0NFBwMkNGcl8hITQyNDM2NzkyNDIuanBnIiBhbGlnbj0iYWJzbWlkZGxlIj48aW1nIHNyYz0iaHR0cHM6Ly9pbWcuYWxpY2RuLmNvbS9pbWdleHRyYS9pMS80MjQzNjc5MjQyL08xQ04wMW9HajZqTTJJOHQ0Vk1wQzAyXyEhNDI0MzY3OTI0Mi5qcGciIGFsaWduPSJhYnNtaWRkbGUiPjxpbWcgc3JjPSJodHRwczovL2ltZy5hbGljZG4uY29tL2ltZ2V4dHJhL2k0LzQyNDM2NzkyNDIvTzFDTjAxQ3BvMzBpMkk4dDRUWERKM0lfISE0MjQzNjc5MjQyLmpwZyIgYWxpZ249ImFic21pZGRsZSI+PGltZyBzcmM9Imh0dHBzOi8vaW1nLmFsaWNkbi5jb20vaW1nZXh0cmEvaTIvNDI0MzY3OTI0Mi9PMUNOMDFFMWhBS2wySTh0NFRYQVFJVF8hITQyNDM2NzkyNDIuanBnIiBhbGlnbj0iYWJzbWlkZGxlIj48aW1nIHNyYz0iaHR0cHM6Ly9pbWcuYWxpY2RuLmNvbS9pbWdleHRyYS9pMy80MjQzNjc5MjQyL08xQ04wMUZaRU5tNTJJOHQ0Vk1vU0ZkXyEhNDI0MzY3OTI0Mi5qcGciIGFsaWduPSJhYnNtaWRkbGUiPjxpbWcgc3JjPSJodHRwczovL2ltZy5hbGljZG4uY29tL2ltZ2V4dHJhL2k0LzQyNDM2NzkyNDIvTzFDTjAxVkdEekFMMkk4dDRXNDdkRW1fISE0MjQzNjc5MjQyLmpwZyIgYWxpZ249ImFic21pZGRsZSI+PGltZyBzcmM9Imh0dHBzOi8vaW1nLmFsaWNkbi5jb20vaW1nZXh0cmEvaTQvNDI0MzY3OTI0Mi9PMUNOMDFOMVZRc3cySTh0NFhGeTRVaF8hITQyNDM2NzkyNDIuanBnIiBhbGlnbj0iYWJzbWlkZGxlIj48aW1nIHNyYz0iaHR0cHM6Ly9pbWcuYWxpY2RuLmNvbS9pbWdleHRyYS9pMi80MjQzNjc5MjQyL08xQ04wMWg3bzJIRjJJOHQ0UlA0cDFRXyEhNDI0MzY3OTI0Mi5qcGciIGFsaWduPSJhYnNtaWRkbGUiPjxpbWcgc3JjPSJodHRwczovL2ltZy5hbGljZG4uY29tL2ltZ2V4dHJhL2k0LzQyNDM2NzkyNDIvTzFDTjAxVkR1dEJTMkk4dDRUWDl4QkdfISE0MjQzNjc5MjQyLmpwZyIgYWxpZ249ImFic21pZGRsZSI+PGltZyBzcmM9Imh0dHBzOi8vaW1nLmFsaWNkbi5jb20vaW1nZXh0cmEvaTEvNDI0MzY3OTI0Mi9PMUNOMDFIdk1wbmUySTh0NFRBaGU3UF8hITQyNDM2NzkyNDIuanBnIiBhbGlnbj0iYWJzbWlkZGxlIj48aW1nIHNyYz0iaHR0cHM6Ly9pbWcuYWxpY2RuLmNvbS9pbWdleHRyYS9pMS80MjQzNjc5MjQyL08xQ04wMUprUnpJWTJJOHQ0WEcxOW04XyEhNDI0MzY3OTI0Mi5qcGciIGFsaWduPSJhYnNtaWRkbGUiPjxpbWcgc3JjPSJodHRwczovL2ltZy5hbGljZG4uY29tL2ltZ2V4dHJhL2kxLzQyNDM2NzkyNDIvTzFDTjAxR0x4RWoxMkk4dDRYRzE1Y09fISE0MjQzNjc5MjQyLmpwZyIgYWxpZ249ImFic21pZGRsZSI+PGltZyBzcmM9Imh0dHBzOi8vaW1nLmFsaWNkbi5jb20vaW1nZXh0cmEvaTIvNDI0MzY3OTI0Mi9PMUNOMDF3dlNxaHoySTh0NFZNcEdCQV8hITQyNDM2NzkyNDIuanBnIiBhbGlnbj0iYWJzbWlkZGxlIj48aW1nIHNyYz0iaHR0cHM6Ly9pbWcuYWxpY2RuLmNvbS9pbWdleHRyYS9pMy80MjQzNjc5MjQyL08xQ04wMWlFQmt3aDJJOHQ0TEF4QUEzXyEhNDI0MzY3OTI0Mi5qcGciIGFsaWduPSJhYnNtaWRkbGUiPjxpbWcgc3JjPSJodHRwczovL2ltZy5hbGljZG4uY29tL2ltZ2V4dHJhL2kyLzQyNDM2NzkyNDIvTzFDTjAxM21XT2xIMkk4dDRZa1dPRlJfISE0MjQzNjc5MjQyLmpwZyIgYWxpZ249ImFic21pZGRsZSI+PGltZyBzcmM9Imh0dHBzOi8vaW1nLmFsaWNkbi5jb20vaW1nZXh0cmEvaTQvNDI0MzY3OTI0Mi9PMUNOMDE4UVpyb1oySTh0NFlrV3JNNV8hITQyNDM2NzkyNDIuanBnIiBhbGlnbj0iYWJzbWlkZGxlIj48aW1nIHNyYz0iaHR0cHM6Ly9pbWcuYWxpY2RuLmNvbS9pbWdleHRyYS9pMS80MjQzNjc5MjQyL08xQ04wMWJsaEJ2YTJJOHQ0VUhiSG1RXyEhNDI0MzY3OTI0Mi5qcGciIGFsaWduPSJhYnNtaWRkbGUiPjxpbWcgc3JjPSJodHRwczovL2ltZy5hbGljZG4uY29tL2ltZ2V4dHJhL2kxLzQyNDM2NzkyNDIvTzFDTjAxZnA5ZmpLMkk4dDRUUTlTMVNfISE0MjQzNjc5MjQyLmpwZyIgYWxpZ249ImFic21pZGRsZSI+PGltZyBzcmM9Imh0dHBzOi8vaW1nLmFsaWNkbi5jb20vaW1nZXh0cmEvaTIvNDI0MzY3OTI0Mi9PMUNOMDF0ODBqUFMySTh0NFRROUpqRl8hITQyNDM2NzkyNDIuanBnIiBhbGlnbj0iYWJzbWlkZGxlIj48aW1nIHNyYz0iaHR0cHM6Ly9pbWcuYWxpY2RuLmNvbS9pbWdleHRyYS9pMy80MjQzNjc5MjQyL08xQ04wMVFXYTV5bTJJOHQ0VzQ5QXM3XyEhNDI0MzY3OTI0Mi5qcGciIGFsaWduPSJhYnNtaWRkbGUiPjxpbWcgc3JjPSJodHRwczovL2ltZy5hbGljZG4uY29tL2ltZ2V4dHJhL2k0LzQyNDM2NzkyNDIvTzFDTjAxZVc0QTVVMkk4dDRWTXB2a2NfISE0MjQzNjc5MjQyLmpwZyIgYWxpZ249ImFic21pZGRsZSI+PGltZyBzcmM9Imh0dHBzOi8vaW1nLmFsaWNkbi5jb20vaW1nZXh0cmEvaTQvNDI0MzY3OTI0Mi9PMUNOMDFvNEFEUmIySTh0NFU2QjlJT18hITQyNDM2NzkyNDIuanBnIiBhbGlnbj0iYWJzbWlkZGxlIj48aW1nIHNyYz0iaHR0cHM6Ly9pbWcuYWxpY2RuLmNvbS9pbWdleHRyYS9pNC80MjQzNjc5MjQyL08xQ04wMXdTTURFaDJJOHQ0Wjd0a3VSXyEhNDI0MzY3OTI0Mi5qcGciIGFsaWduPSJhYnNtaWRkbGUiPjxpbWcgc3JjPSJodHRwczovL2ltZy5hbGljZG4uY29tL2ltZ2V4dHJhL2k0LzQyNDM2NzkyNDIvTzFDTjAxdFhlY25sMkk4dDRUUTlXQ1hfISE0MjQzNjc5MjQyLmpwZyIgYWxpZ249ImFic21pZGRsZSI+PGltZyBzcmM9Imh0dHBzOi8vaW1nLmFsaWNkbi5jb20vaW1nZXh0cmEvaTEvNDI0MzY3OTI0Mi9PMUNOMDFiVk12VGgySTh0NFRRQmZIZV8hITQyNDM2NzkyNDIuanBnIiBhbGlnbj0iYWJzbWlkZGxlIj48aW1nIHNyYz0iaHR0cHM6Ly9pbWcuYWxpY2RuLmNvbS9pbWdleHRyYS9pMi80MjQzNjc5MjQyL08xQ04wMXVNUU9NaDJJOHQ0VUhkTWdiXyEhNDI0MzY3OTI0Mi5qcGciIGFsaWduPSJhYnNtaWRkbGUiPjxpbWcgc3JjPSJodHRwczovL2ltZy5hbGljZG4uY29tL2ltZ2V4dHJhL2kzLzQyNDM2NzkyNDIvTzFDTjAxbG93UnBoMkk4dDRZa1d2V3VfISE0MjQzNjc5MjQyLmpwZyIgYWxpZ249ImFic21pZGRsZSI+PC9wPg==
Продавец:家韵三特专卖店
Адрес:Гуандун
Рейтинг:

Всего отзывов:0
Положительных:0
Выберите вариацию / цвет
Добавить в корзину
- Информация о товаре
- Фотографии
| Цвет: | [Среда] антибактериальная и заплесневелая пшеничная доска с двойной рубкой, [Среда] Антибактериальная и заплесневелая пшеница двойная режущая плата+рама режущей пластины, Большая антибактериальная двусторонная разделочная доска, Большая антибактериальная двусторонная разделочная доска, [Среда] Новая двойная режущая доска из нержавеющей стали 304, [Среда] Новая антибактериальная 304 из нержавеющей стали двойной режущей доски+стойка стойки, Из нержавеющей стали, большой, антибактериальный, двусторонний, Из нержавеющей стали, большой, антибактериальный, двусторонний, [Среда] 304 нержавеющая сталь [двусторонняя утолщенная 22 мм] 1-3 Семейство 43*29, [Среда] 304 нержавеющая сталь [двусторонняя утолщение 22 мм] 1-3 Семейство Семейства 43*29+РЕЗУЧАЯ ПАРТА |